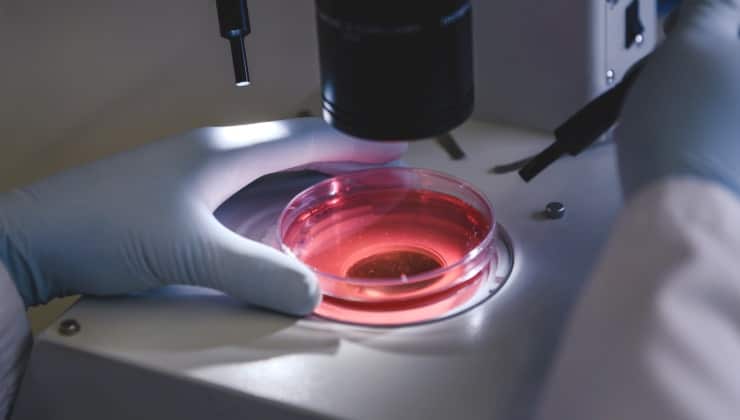

Environmental Toxicology Testing for Sustainable Solutions
INDIGO Biosciences offers advanced Environmental Toxicology services to help organizations evaluate the potential ecological and human health impacts of chemicals, pollutants, and other environmental contaminants. Our in vitro assays provide reliable, high-throughput data to assess environmental hazards, ensuring that your products and solutions are safe and sustainable for the future.

Get Reliable Data & Clear Reports from Our Expert Scientists
Sustainability Focus
We provide insights into the environmental and ecological impacts of your products, supporting sustainable development.
Comprehensive Testing
From endocrine disruptors to ecotoxicology, we offer a broad range of testing services to address various environmental risks
Fast Screening & Data Delivery
Access crucial information quickly with INDIGO's Environmental Toxicology services.
Get Started in Three Simple Steps
Design your next study rapidly and confidently with our expert team.

Step 1: Request a Quote in One Click
Fill out a Request a Quote form and tell us more about your study and objectives.

Step 2: Design Your Service Study with Our Scientists
Receive your quote and a custom draft of your Service Work Order.
Review and adjust to fit your needs.

Step 3: Send Your Samples and Get Your Results
Provide your samples or compounds, and we will do the rest.
Receive a complete data package and clear study reports in record time!
See What Our Customers Have to Say